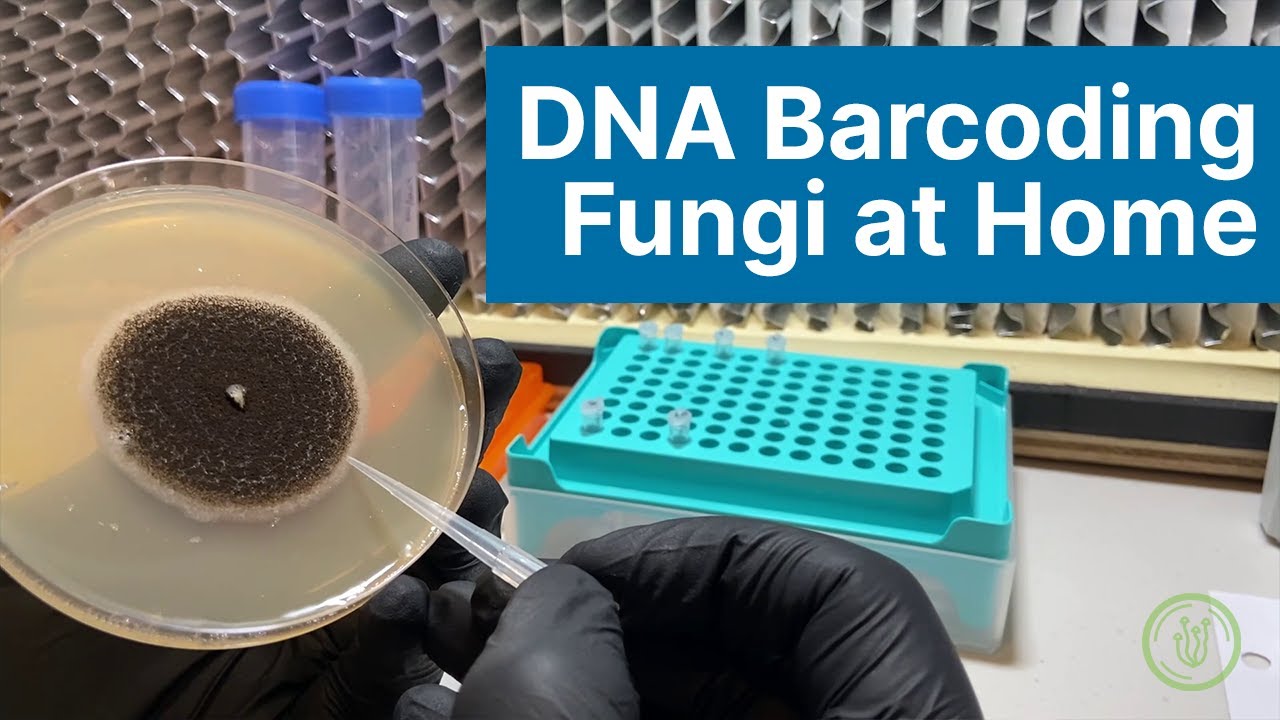

Super fascinating sector of the fungal kingdom, when so many species have not been studied just yet, it is believed it is due to them living internally in plants. This amazing video of a someone studying endophytes from sea flora is where my interest began to peak. Then I can not remember the read I did, but it was about the study of fungi and how it helped rejuvenate plant life in New Orleans after Hurricane Katrina